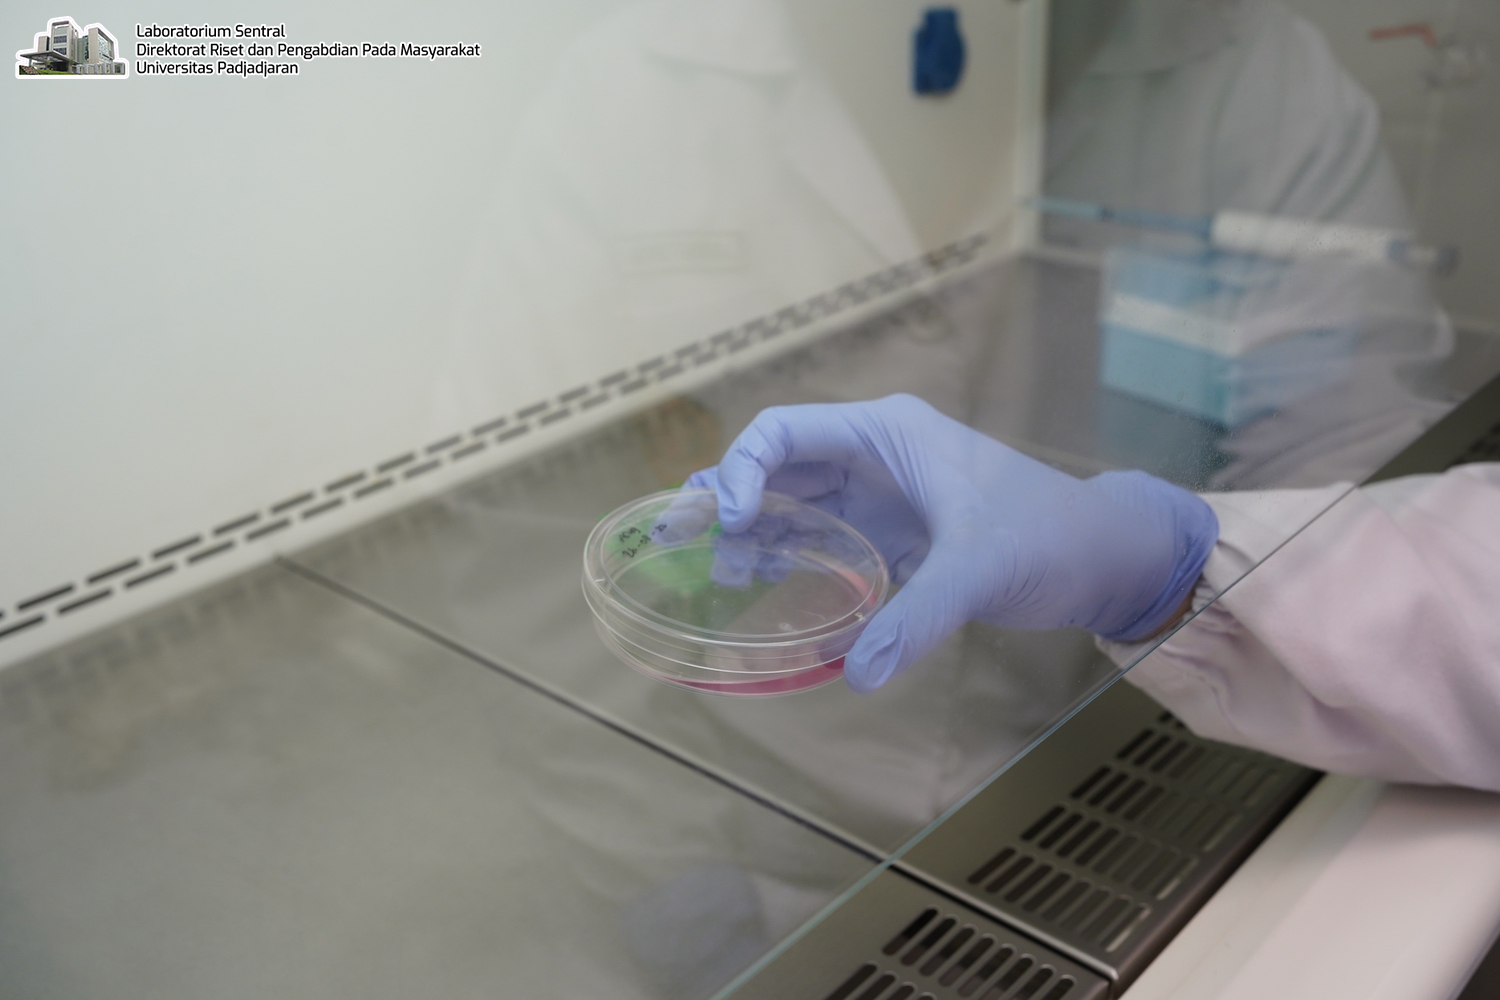
Product Image

Biological Safety Cabinet JSR
Biological safety cabinet digunakan sebagai ruang kerja preparasi bahan-bahan biologis yang berbahaya seperti bakteri, virus serta asam nukleat yang membutuhkan Biosafety level 1, 2, 3.
Hanya untuk penggunaan dalam lingkungan Laboratorium Sentral.
Kategori: Aktivitas Biologi
Spesifikasi
- Merk: JSR
- Class II Type A2
- Biological safety cabinet dilengkapi dengan vertical laminar flow